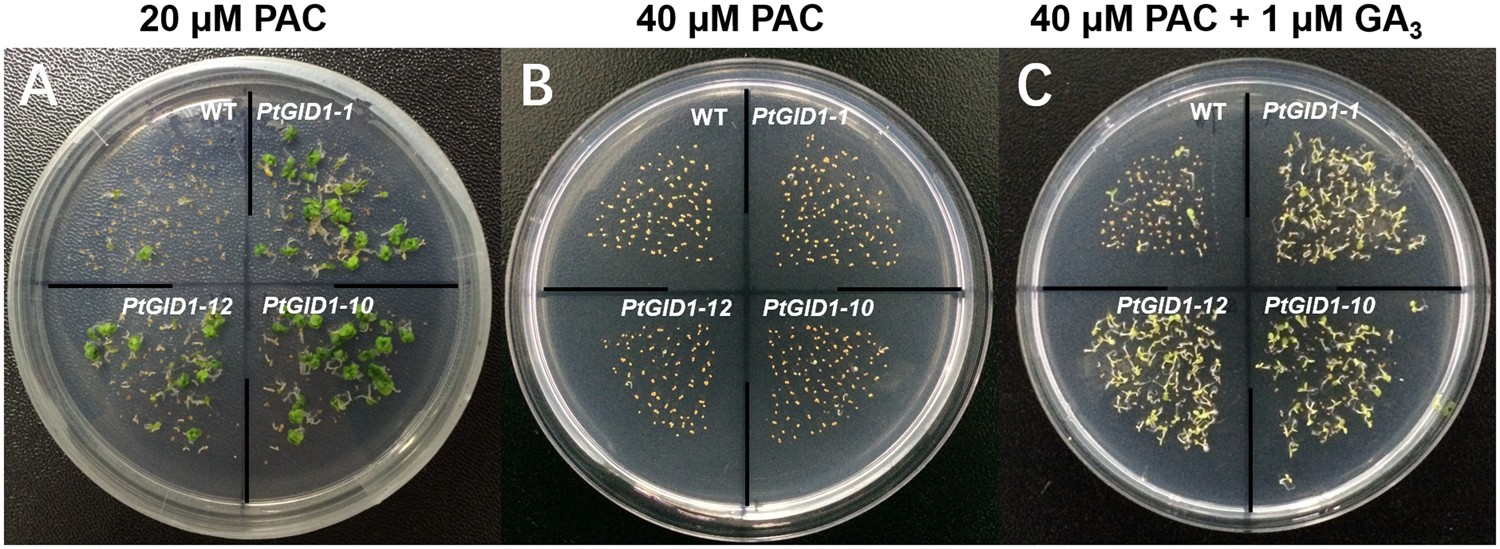
Figure 4

Figure 4
From: The gibberellin GID1-DELLA signalling module exists in evolutionarily ancient conifers
PtGID1 overexpression rescues Arabidopsis plants grown on medium containing the GA biosynthesis inhibitor PAC. Wild-type (WT) plants and three lines of PtGID1 plants (PtGID1-1, PtGID1-10, and PtGID1-12) were sown on MS-agar with (A) 20 μM PAC, (B) 40 μM PAC, or (C) 40 μM PAC and 1 μM GA3, and incubated at 22 °C. Scale bar, 1 cm.
